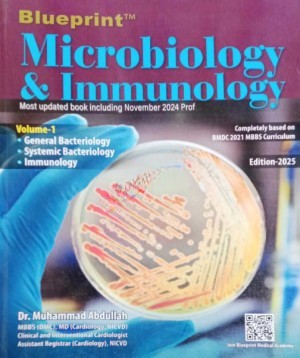

Blueprint Microbiology & Immunology Volume 1-2
1,200.00৳
Author: Dr. Muhammed Abdullah
Edition: 14th Edition 2025
Publisher: Blueprint Publication
Author: Dr. Muhammed Abdullah
Edition: 14th Edition 2025
Publisher: Blueprint Publication
Be the first to review “Blueprint Microbiology & Immunology Volume 1-2”
Your Recently

Reviews
There are no reviews yet.